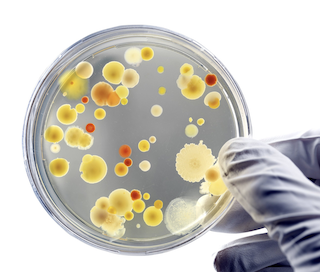

Founder & CEO · Adjunct Research Scientist (AICAD)
Adv. Rahul
Prataprao Padwal
Sustainability Leader · Research Scientist · Organic Fertilizer Innovator
Over 22 years of hands-on expertise in integrated waste management, soil health restoration, and regenerative agriculture — bridging scientific research, field implementation, and global sustainability partnerships.

Multidisciplinary expertise across agriculture, sustainability, and law
1. A Study on Conversion of Raw Cow Manure into Nutritious Organic Fertilizer for Quality Enhancement
DOI – Official Publication Record
ShodhKosh Journal Page
ResearchGate Publication
Semantic Scholar Index
Academia.edu Publication
2. Life Cycle Assessment and Process Optimization of Urban Organic Waste-Based Fertilizers
A practical walkthrough of India's National Programme for Organic Production certification process, covering documentation, inspection, and compliance requirements.
An evidence-based examination of agronomic, economic, and market barriers farmers face when shifting from conventional to organic production systems.
Types, application methods, nutrient profiles, and agronomic benefits of organic fertilizers for sustainable soil fertility management.
How bacterial, fungal, and protozoan communities drive nutrient cycling, disease suppression, and long-term soil health.
An overview of the core principles, inputs, and practices that define certified organic agriculture worldwide.
Why soil biological activity, structure, and chemistry are foundational to food security and environmental sustainability.
Featured in Floramarket — International Agricultural Publication, Spain
The Element Phosphorus: A Pillar of Crop Nutrition — Verdimedia Editorial
Agriculture Today — 2024 Edition
Sakal AgroVon — An Integrated Approach for Sustainable Agriculture
Sakal AgroVon — Protect Soil Health for Sustainable Agriculture
Samarth Bharat — Media Feature
Sakal AgroVon - Composting from Waste to Receive a Major Boost
